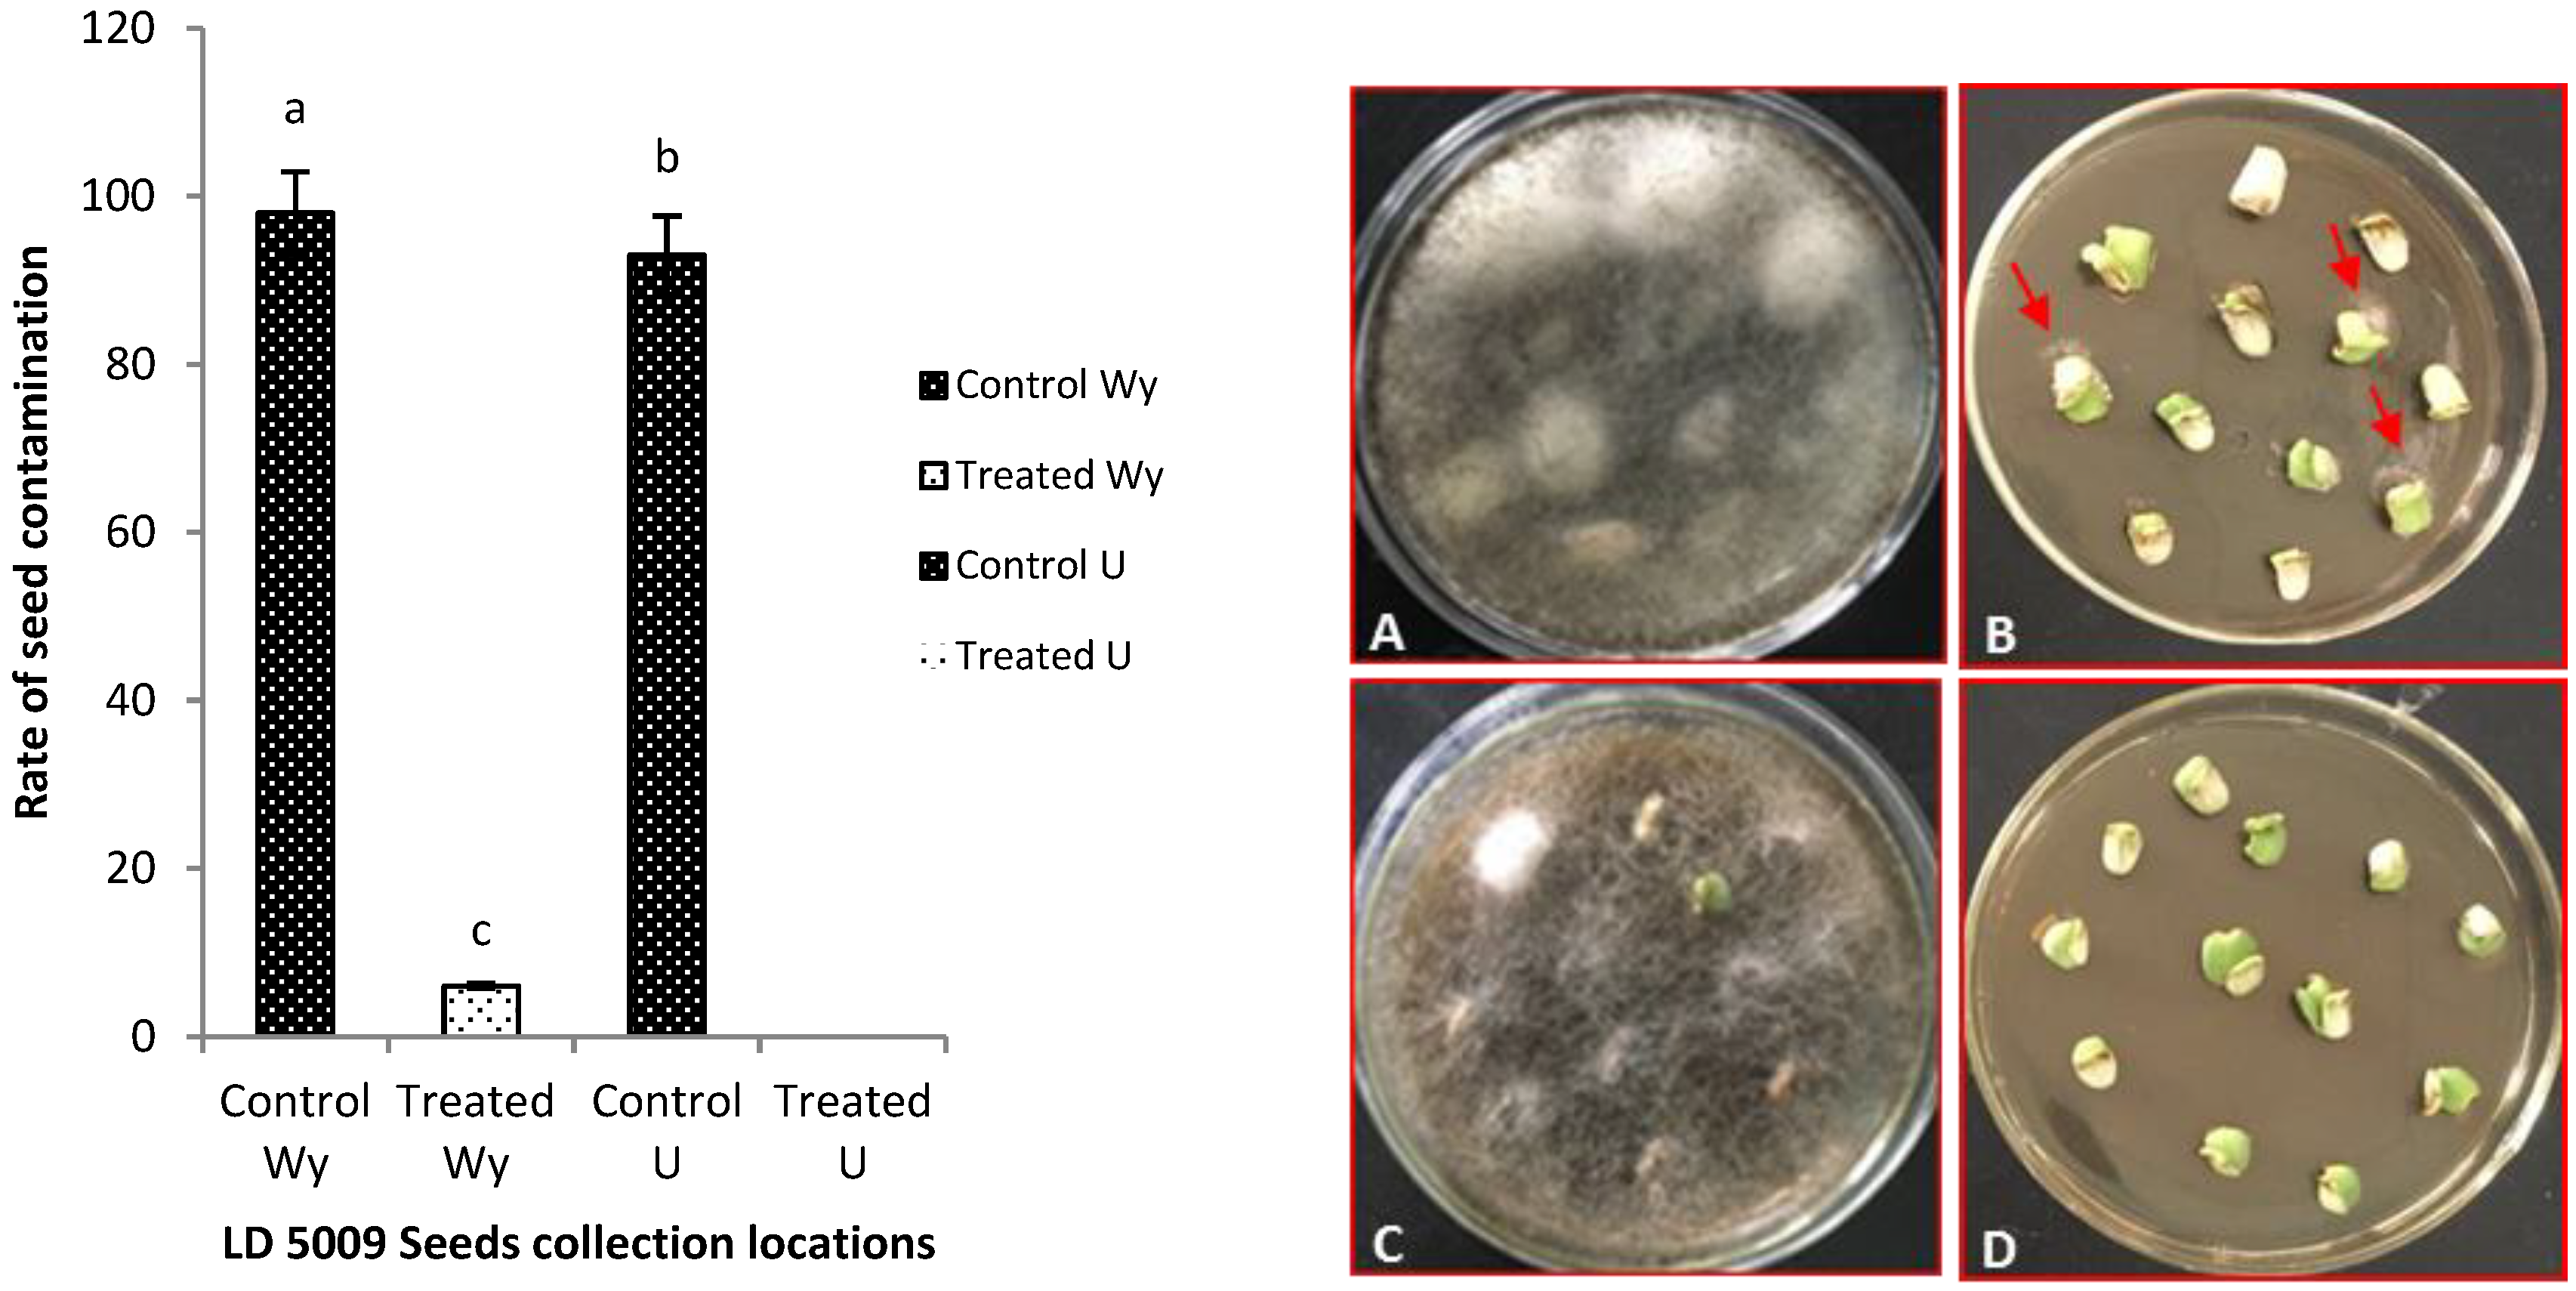
Pathogens 09 00029 g005 Pathogens 09 00029 g005

Fungicide Treatments to Control Seed-borne Fungi of Sunflower Seeds
Abstract
1. Introduction
2. Results
2.1. Overview of Contamination Rate and Percentage Range of Contaminated Sunflower Varieties
2.2. Morphological and Molecular Identification of Fungi Isolated from Seed Coats
2.3. Fungicide Screening and Optimization of Conditions for Seed Pretreatment
2.4. Effects of Flusilazole Pretreatment on Contaminated Sunflower Seeds
3. Discussion
3.1. Morphological and Molecular Identification of Fungi Isolated from Seed Coats
3.2. Fungicide Screening, Optimization, and Seed Pretreatment
4. Material and Method
4.1. Sample Collection
4.2. Culture Media
4.3. Determining the Contamination Rate of Sunflower Seed Coats
4.4. Fungi Isolation and Identification
4.5. Fungicide Screening
4.6. Effect of Flusilazole on Contaminated Sunflower Seed Coats
4.7. Seed Pretreatment Method
5. Conclusions
Supplementary Materials
Author Contributions
Funding
Acknowledgments
Conflicts of Interest
References
- Weiss, E.A. (Ed.) Sunflower. In Oilseed Crops, 2nd ed.; Blackwell Science Ltd.: London, UK, 2000; pp. 205–243. [Google Scholar]
- Mukhtar, I. Sunflower disease and insect pests in Pakistan. Afr. Crop Sci. J. 2009, 17, 109–118. [Google Scholar] [CrossRef]
- Mathur, S.B.; Manandhar, H.K. Fungi in Seeds; The Danish Government Institute of Seed Pathology for Developing Countries: Copenhagen, Denmark, 2003.
- Sangawan, M.; Metha, N.; Saharan, G. Diseases of Oil Seed Crops; Industry Publication Co.: Pune, India, 2005; pp. 11–15. [Google Scholar]
- Harrison, J.A.C.; Isaac, I. Survival of the causal agents of ‘early-dying disease’ (verticillium wilt) of potatoes. Ann. Appl. Biol. 1969, 63, 277–288. [Google Scholar] [CrossRef]
- Rao, L. Studies on Seed-Borne Fungal Diseases of Sunflower and Their Management with Special References to the Alternaria Blight. Ph.D. Thesis, University of Agricultural Sciences, Dharwad, India, 2006. [Google Scholar]
- Klisiewicz, J.M. Survival, and dissemination of Verticillium in infected safflower seed. Phytopathology 1975, 65, 696–698. [Google Scholar] [CrossRef]
- Vallad, G.E.; Subbarao, K.V. Colonization of resistant and susceptible lettuce cultivars by a green fluorescent protein-tagged isolate of Verticillium dahliae. Phytopatholgy 2008, 98, 871–885. [Google Scholar] [CrossRef]
- Allen, R.M. Cotton seeds are capable of carrying Verticillium. Plant Dis. 1951, 35, 11–12. [Google Scholar]
- Du Toit, L.; Derie, M.; Hernandez-Perez, P. Verticillium wilt in spinach seed production. Plant Dis. 2005, 89, 4–11. [Google Scholar] [CrossRef]
- Maruthachalam, K.; Klosterman, S.J.; Anchieta, A.; Mou, B.; Subbarao, K.V. Colonization of spinach by Verticillium dahliae and effects of pathogen localization on the efficacy of seed treatments. Phytopathology 2013, 103, 268–280. [Google Scholar] [CrossRef]
- Zhang, Y.; Zhang, J.; Gao, J.; Zhang, G.; Yu, Y.; Zhou, W.; Chen, W.; Zhao, J. The colonization process of sunflower by a green fluorescent protein-tagged isolate of Verticillium dahliae and its seed transmission. Plant Dis. 2018, 102, 1772–1778. [Google Scholar] [CrossRef]
- Ghoneem, K.M.; Ezzat, S.M.; El-Dadamony, N.M. Seed-borne fungi of sunflower in Egypt with reference to pathogenic effects and their transmission. Plant Pathol. J. 2014, 13, 278–284. [Google Scholar] [CrossRef]
- Sharfun-Nahar, M.M.; Hashmi, M.H. Seed borne mycoflora of sunflower (Helianthus annuus L.). Pak. J. Bot. 2005, 37, 451–457. [Google Scholar]
- Srinivas, A.; Pushpavathi, B.; Lakshmi, B.K.M.; Shashibhushan, V. Detection of seed borne mycoflora of sunflower (Helianthus annuus L.). Pharma Innov. J. 2017, 6, 256–259. [Google Scholar]
- Lan, W.W.; Chen, Q.; Wang, W.J.; Wu, X.H. Advances in the sunflower Alternaria black spot and its integrated management. Plant Prot. 2009, 35, 24–29. (In Chinese) [Google Scholar]
- Ramusi, M.; Flett, B. Foliar Diseases of Sunflower: Alternaria Leaf Blight, Brown Rust and Septoria Leaf Spot; ARC-Grain Crops Institute: Potchefstroom, South Africa, 2014; Available online: https://www.grainsa.co.za/foliar-diseases-of-sunflower:-alternaria-leaf-blight,-brown-rust-and-septoria-leaf-spot (accessed on 10 April 2019).
- Kgatle, M.; Truter, M.; Ramusi, M.; Flett, B.; Aveling, T. Alternaria alternata, the causal agent of leaf blight of sunflower in South Africa. Eur. J. Plant Pathol. 2018, 17, 1402–1407. [Google Scholar] [CrossRef]
- Masirevic, S.; Jasnic, S. Wilt of sunflower. Biljn. Lek. Plant Dr. 2006, 34, 333–335. [Google Scholar]
- Pegg, G.F.; Brady, B.L. Verticillium Wilts; CABI: Wallingford, UK, 2002. [Google Scholar]
- Krikun, J.; Bernier, C.C. Infection of several crop species by two isolates of Verticillium dahliae. Can. J. Plant Pathol. 1987, 9, 241–245. [Google Scholar] [CrossRef]
- Mol, L.; Van Halteren, J.M.; Scholte, K.; Struik, P.C. Effects of crop species, crop cultivars, and isolates of Verticillium dahliae on the population of microsclerotia in the soil, and consequences for crop yield. Plant Pathol. 1996, 45, 205–221. [Google Scholar] [CrossRef]
- Atallah, Z.K.; Hayes, R.J.; Subbarao, K.V. Fifteen years of verticillium wilt of lettuce in America’s salad bowl: A tale of immigration, subjugation, and abatement. Plant Dis. 2011, 95, 784–792. [Google Scholar] [CrossRef]
- Malcolm, G.M.; Kuldau, G.A.; Gugino, B.K.; Jiménez-Gasco, M.M. Hidden host plant associations of soilborne fungal pathogens: An ecological perspective. Phytopathology 2013, 103, 538–544. [Google Scholar] [CrossRef]
- Singh, V.K.; Pandey, P. Physical methods in management of plant diseases. Plant Dis. 2012, 10, 1. [Google Scholar] [CrossRef]
- Palti, J. Cultural Practices, and Infectious Crop Disease; Springer Varlag: Berlin, Germany, 1981; p. 343. [Google Scholar]
- Keerio, A.; Nizamani, A.Z.; Hussain, S.; Rafiq, M.; Iqbal, S.; Keerio, A.-D. Efficacy of some chemical fungicides against fusarium wilt of sunflower in-vitro condition course by Fusarium oxysporum. Int. J. Bot. Stud. 2017, 2, 80–85. [Google Scholar]
- Sygenta Canada Inc. Cruiser Maxx Cereals. Approved Pamphlet Cruiser Maxx Cereals; Sygenta Canada Inc.: Calgary, AB, Canada, 2012; pp. 1–9. Available online: https://www.syngenta.ca/pdf/labels/Cruiser_Maxx_Cereals_29192_en_pamphlet.pdf (accessed on 4 May 2019).
- BASF. Stamina F3 Cereals Fungicide Seed Treatment Advanced Seed Enhancement Guide; BASF: Ludwigshafen, Germany, 2016; pp. 9–11. Available online: https://agriculture.basf.com/us/en/CropProtection/Stamina.html (accessed on 10 April 2019).
- Munkvold, G.P.; O’Mara, J.K. Laboratory and growth chamber evaluation of fungicidal seed treatments for maize seedling blight caused by Fusarium species. Plant Dis. 2002, 86, 143–150. [Google Scholar] [CrossRef] [PubMed]
- Briggs, K.G.; Dunn, G.J. Variation amongst Canadian six-row spring barley cultivars for germination and emergence characteristics in controlled environments and the field. Can. J. Plant Sci. 2000, 80, 247–253. [Google Scholar] [CrossRef]
- Kadow, K.J. Seed transmissions of verticillium wilt of eggplants and tomatoes. Phytopathology 1934, 24, 1265–1268. [Google Scholar]
- Wang, Y.-J.; Gao, F.-Z.; Cao, X.; Xu, C.-G.; Zhou, H.-Y.; Jing, L.; Zhao, J. Resistance evaluation of different sunflower cultivars to Sclerotinia sclerotiorum. Chin. J. Oil Crop Sci. 2010, 32, 540–545. [Google Scholar]
- Robertson, J.A.; Burns, E.E. Use of sunflower seed in food products. Crit. Rev. Food Sci. Nutr. 1975, 6, 201–240. [Google Scholar] [CrossRef]
- Mandel, J.R.; Dechaine, J.M.; Marek, L.F.; Burk, J.M. Genetic diversity and population structure in cultivated sunflower and a comparison to its wild progenitor, Helianthus annuus L. Theor. Appl. Genet. 2011, 123, 693–704. [Google Scholar] [CrossRef]
- Göre, M.E.; Erdoğan, O.; Altin, N.; Aydin, M.H.; Caner, O.K.; Filizer, F.; Buyukdogerlioglu, A. Seed transmission of verticillium wilt of cotton. Pythoparasitica 2011, 39, 285–292. [Google Scholar] [CrossRef]
- Platz, G.J.; Meldrum, S.I.; Webb, N.A. Chemical control of seed-borne diseases of barley. In Proceedings of the 10th Australian Barley Technical Symposium, Canberra, Australia, 16–20 September 2001. [Google Scholar]
- Kabir, Z.; Bhat, R.G.; Subbarao, K.V. Comparison of media for recovery of Verticillium dahliae from the soil. Plant Dis. 2004, 88, 49–55. [Google Scholar] [CrossRef]
- Doyle, J.; Doyle, J.L. Isolation of plant DNA from fresh tissue. Focus 1990, 12, 13–15. [Google Scholar]
- White, T.J.; Bruns, T.; Lee, S.; Taylor, J. Amplification and direct sequencing of fungal ribosomal RNA genes for phylogenetics. In PCR Protocols: A Guide to Methods and Applications; Innis, M.A., Gelfand, D.H., Sninsky, J.J., White, T.J., Eds.; Academic Press: New York, NY, USA, 1990; pp. 315–322. [Google Scholar]
- Inderbitzin, P.; Davis, R.M.; Bostock, R.M.; Subbarao, K.V. Identification and differentiation of Verticillium species and V. longisporum lineages by simplex and multiplex PCR assays. PLoS ONE 2013, 8, 65990. [Google Scholar] [CrossRef]
- O’Donnell, K.; Kistler, H.C.; Cigelnik, E.; Ploetz, R.C. Multiple evolutionary origins of the fungus causing Panama disease of banana: Concordant evidence from nuclear and mitochondrial gene genealogies. Proc. Natl. Acad. Sci. USA 1998, 95, 2044–2049. [Google Scholar] [CrossRef] [PubMed]
- Kordalewska, M.; Brillowska-Dąbrowska, A.; Jagielski, T.; Dworecka-Kaszak, B. PCR and real-time PCR assays to detect fungi of Alternaria alternata species. Acta. Biochim. Pol. 2015, 62, 707–712. [Google Scholar] [CrossRef] [PubMed]
- FRAC Code List. Fungicides Sorted by Mode of Action (Including FRAC Code Numbering); Fungicide Resistance Action Committee (FRAC): Brussels, Belgium, 2018; pp. 3–14. Available online: https://www.frac.info/what-s-new (accessed on 13 April 2018).

| Sunflower Variety | The Percentage Rate of Pathogenic Contamination (%) | Sunflower Variety | The Percentage Rate of Pathogenic Contamination (%) | ||||||
|---|---|---|---|---|---|---|---|---|---|
| Confectionery Seed Group | V. Dahliae | Rhizopus Spp. | Alternaria Spp. | Fusarium Spp. | Confectionery Seed Group | V. Dahliae | Rhizopus Spp. | Alternaria Spp. | Fusarium Spp. |
| G1AXR | 57 | 15 | 15 | 0 | FST 7331 | 8 | 76 | 0 | 10 |
| H 16-14 | 47 | 0 | 14 | 6 | Guaner 1 | 8 | 70 | 0 | 0 |
| H 16-1 | 42 | 8 | 35 | 0 | H 16-22 | 7 | 56 | 0 | 23 |
| XKS 1618 | 42 | 0 | 0 | 0 | LD 139 | 7 | 0 | 0 | 0 |
| XKS 1619 | 37 | 0 | 0 | 0 | H 16-20 | 6 | 0 | 0 | 0 |
| Jishikui 3 | 35 | 0 | 0 | 0 | G2AX12 | 5 | 0 | 0 | 0 |
| LSK 20 | 35 | 0 | 58 | 0 | Xinhechang 968 | 5 | 0 | 0 | 0 |
| LSK 21 | 32 | 0 | 0 | 0 | Keyang 4 | 5 | 0 | 0 | 0 |
| Xiankui 363 | 32 | 15 | 23 | 0 | Fengwo T33 | 5 | 0 | 0 | 0 |
| Kaifurui 2 | 28 | 0 | 19 | 0 | FST 7333 | 5 | 70 | 10 | 8 |
| Likuifu 3 | 27 | 0 | 0 | 0 | LJ 316 | 3 | 0 | 0 | 0 |
| TH 2511 | 27 | 52 | 0 | 13 | Keyang 2 | 3 | 0 | 0 | 0 |
| Longkui 363 | 25 | 0 | 0 | 0 | Jiarui 3 | 3 | 0 | 0 | 18 |
| GKS 1601 | 21 | 0 | 0 | 0 | JC 361 | 3 | 0 | 0 | 0 |
| Gankui 2 | 20 | 0 | 80 | 0 | H 16-24 | 2 | 0 | 0 | 0 |
| A1X107 | 20 | 0 | 0 | 0 | Chikui 7002 | 2 | 0 | 43 | 0 |
| Chikui 7001 | 18 | 0 | 22 | 0 | ZH 9021 | 2 | 85 | 0 | 9 |
| Chikui 7004 | 18 | 0 | 57 | 0 | Jiarui 1 | 2 | 0 | 90 | 0 |
| ZH 363 | 17 | 58 | 10 | 6 | TF 9041 | 2 | 0 | 0 | 0 |
| Z1AXR | 10 | 0 | 0 | 0 | Ruoshui T339 | 2 | 84 | 0 | 0 |
| A1-ZX 422 | 10 | 0 | 0 | 0 | JK 601 | 0 | 0 | 0 | 0 |
| Dikui 9233 | 10 | 15 | 63 | 0 | Chikui 7003 | 0 | 0 | 0 | 0 |
| Z2AXR | 9 | 0 | 0 | 0 | DR 146832 | 0 | 0 | 0 | 0 |
| Jishikui 2 | 8 | 65 | 0 | 0 | LD 7009 | 0 | 0 | 0 | 0 |
| FST 331 | 8 | 0 | 0 | 0 | TH 5363 | 0 | 0 | 0 | 0 |
| Mengkui 18 | 8 | 0 | 0 | 0 | LD 5009 | 0 | 0 | 0 | 0 |
| Sunflower Variety | The Percentage Rate of Pathogenic Contamination (%) | Sunflower Variety | The Percentage Rate of Pathogenic Contamination (%) | ||||||
|---|---|---|---|---|---|---|---|---|---|
| Oilseed Group | V. Dahliae | Rhizopus Spp. | Alternaria Spp. | Fusarium Spp. | Oilseed Group | V. Dahliae | Rhizopus Spp. | Alternaria Spp. | Fusarium Spp. |
| KY 2 | 22 | 0 | 0 | 0 | F 53 | 3 | 0 | 0 | 0 |
| KY 3 | 17 | 0 | 0 | 0 | S 67 | 2 | 0 | 0 | 0 |
| ChiKY 11-52 | 12 | 0 | 0 | 0 | KY 11-23 | 1 | 0 | 0 | 0 |
| France -1 | 10 | 0 | 0 | 0 | New breed 26 | 0 | 0 | 0 | 0 |
| Longkuiza 2 | 7 | 0 | 0 | 0 | LKZ 13 | 0 | 0 | 0 | 0 |
| KY 1 | 3 | 0 | 0 | 0 | LKZ 14-4 | 0 | 0 | 0 | 0 |
| KF 3009 | 3 | 0 | 0 | 0 | Chikui CY 101 | 0 | 0 | 0 | 0 |
| XKY 1606 | 3 | 0 | 0 | 0 | Longkuiza | 0 | 0 | 0 | 0 |
| NKP 218 | 3 | 0 | 0 | 0 | |||||
| Name of the Genus of Pathogen | Species Type | GenBank Accession Numbers |
|---|---|---|
| Alternaria spp. | Alternaria tenuissima | MN853399 |
| Alternaria alternata | MN853394 | |
| Alternaria helianthiinficiens | MN853403 | |
| Alternaria longipes | MN853398 | |
| Alternaria tamaricis | MN853404 | |
| Fusarium spp. | Fusarium oxysporum | MN853482 |
| Fusarium incarnatum | MN853391 | |
| Fusarium proliferatum | MN853400 | |
| Cladiosporium spp. | Cladiosporium cladosporioides | MN853393 |
| Verticillium spp. | Verticillium dahliae | MN853401 |
| Non-determined | Non-determined | MN853402 |
| Fungicide Trade Name | Concentration (µg/mL) | Concentration Per Value (x) | Inhibition Rate % | Probability Value (Y) | Virulence Regression Equation | EC50 (µg/mL) | R |
|---|---|---|---|---|---|---|---|
| Carbendazim | 5 | 0.70 | 72.89% | 5.6098 | y = −0.8884x + 6.9684 | 164.3 | 0.916 |
| 10 | 1.00 | 78.29% | 5.7824 | ||||
| 20 | 1.30 | 82.76% | 5.9463 | ||||
| 40 | 1.60 | 92.63% | 6.4466 | ||||
| Triadimefon | 2 | 0.30 | 63.51% | 5.3451 | y = −0.3464x + 5.7089 | 111.3 | 0.9104 |
| 3 | 0.48 | 65.17% | 5.3907 | ||||
| 7 | 0.85 | 69.25% | 5.5015 | ||||
| 13.33 | 1.12 | 74.08% | 5.6464 | ||||
| Caprio F-500 (Pyraclostrobin) | 0.7 | −0.15 | 32.84% | 4.5546 | y = −0.4693x + 5.955 | 131.9 | 0.9798 |
| 7 | 0.85 | 55.54% | 5.1383 | ||||
| 70 | 1.85 | 74.36% | 5.6557 | ||||
| 700 | 2.85 | 82.76% | 5.9464 | ||||
| Flusilazole | 0.013 | −1.89 | 62.04% | 5.3055 | y = −0.1065x + 5.2019 | 78.7 | 0.9937 |
| 0.025 | −1.60 | 63.51% | 5.3451 | ||||
| 0.05 | −1.30 | 64.49% | 5.3719 | ||||
| 0.10 | −1.00 | 65.58% | 5.4016 |
© 2019 by the authors. Licensee MDPI, Basel, Switzerland. This article is an open access article distributed under the terms and conditions of the Creative Commons Attribution (CC BY) license (http://creativecommons.org/licenses/by/4.0/).
Share and Cite
Addrah, M.E.; Zhang, Y.; Zhang, J.; Liu, L.; Zhou, H.; Chen, W.; Zhao, J. Fungicide Treatments to Control Seed-borne Fungi of Sunflower Seeds. Pathogens 2020, 9, 29. https://doi.org/10.3390/pathogens9010029
Addrah ME, Zhang Y, Zhang J, Liu L, Zhou H, Chen W, Zhao J. Fungicide Treatments to Control Seed-borne Fungi of Sunflower Seeds. Pathogens. 2020; 9(1):29. https://doi.org/10.3390/pathogens9010029
Chicago/Turabian StyleAddrah, Mandela Elorm, Yuanyuan Zhang, Jian Zhang, Lin Liu, Hongyou Zhou, Weidong Chen, and Jun Zhao. 2020. "Fungicide Treatments to Control Seed-borne Fungi of Sunflower Seeds" Pathogens 9, no. 1: 29. https://doi.org/10.3390/pathogens9010029
APA StyleAddrah, M. E., Zhang, Y., Zhang, J., Liu, L., Zhou, H., Chen, W., & Zhao, J. (2020). Fungicide Treatments to Control Seed-borne Fungi of Sunflower Seeds. Pathogens, 9(1), 29. https://doi.org/10.3390/pathogens9010029

